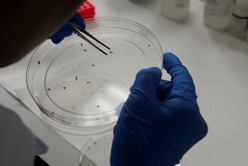

En el marco del Día Internacional contra el Dengue, la ciudad de Santa Fe realizaba este martes una jornada de concientización en la Plaza Pueyrredón, de 10 a 13 horas. La propuesta, organizada por el municipio junto a la Provincia y la Universidad Nacional del Litoral (UNL), busca visibilizar el trabajo articulado que se viene realizando y preparar a la comunidad de cara a la próxima temporada de mayor circulación del virus.
Día Internacional contra el Dengue: en Santa Fe los casos bajaron un 99% respecto al año pasado
Con acciones de prevención, monitoreo y bloqueo, el municipio logró reducir drásticamente la circulación de la enfermedad.


La actividad incluyó stands informativos, asesoramiento y talleres abiertos a los vecinos, con foco en tres ejes: monitoreo entomológico, que permite medir la presencia del mosquito transmisor; prevención, a través de las campañas de descacharrado; y bloqueo rápido, en caso de detectarse un positivo. Además, la UNL participó con propuestas de salud integral y el Centro de Salud Candioti brindará información sobre la vacuna contra el dengue.

Números alentadores
Según datos del municipio, en la temporada 2024-2025 los casos de dengue se redujeron en un 99% respecto al período anterior. Este resultado se atribuye a un conjunto de intervenciones que incluyeron más de 25 talleres escolares, 87 capacitaciones en instituciones, 77 presencias del stand de prevención en eventos y la implementación de ovitrampas para monitorear la actividad del mosquito Aedes Aegypti.

A su vez, se realizaron descacharrados asistidos en puntos críticos como el Cementerio Municipal y en barrios donde hubo brotes en la temporada pasada. También se llevaron adelante 21 bloqueos focales ante casos positivos; el último fue el 12 de mayo y desde entonces no se registraron nuevos contagios.
En paralelo, se firmó un convenio con la Facultad de Ingeniería y Ciencias Hídricas de la UNL para ampliar el sistema de monitoreo entomológico, incorporando trampas para mosquitas adultas.
Mirada hacia adelante
Con estas cifras favorables, el municipio destacó que septiembre marcará el inicio de las primeras acciones de descacharrado asistido para la temporada 2025-2026. La jornada en Plaza Pueyrredón será, además, una invitación a toda la comunidad a reforzar el compromiso en la lucha contra el dengue, adoptando hábitos saludables y cuidando el ambiente.









Dejanos tu comentario
Los comentarios realizados son de exclusiva responsabilidad de sus autores y las consecuencias derivadas de ellos pueden ser pasibles de las sanciones legales que correspondan. Evitar comentarios ofensivos o que no respondan al tema abordado en la información.